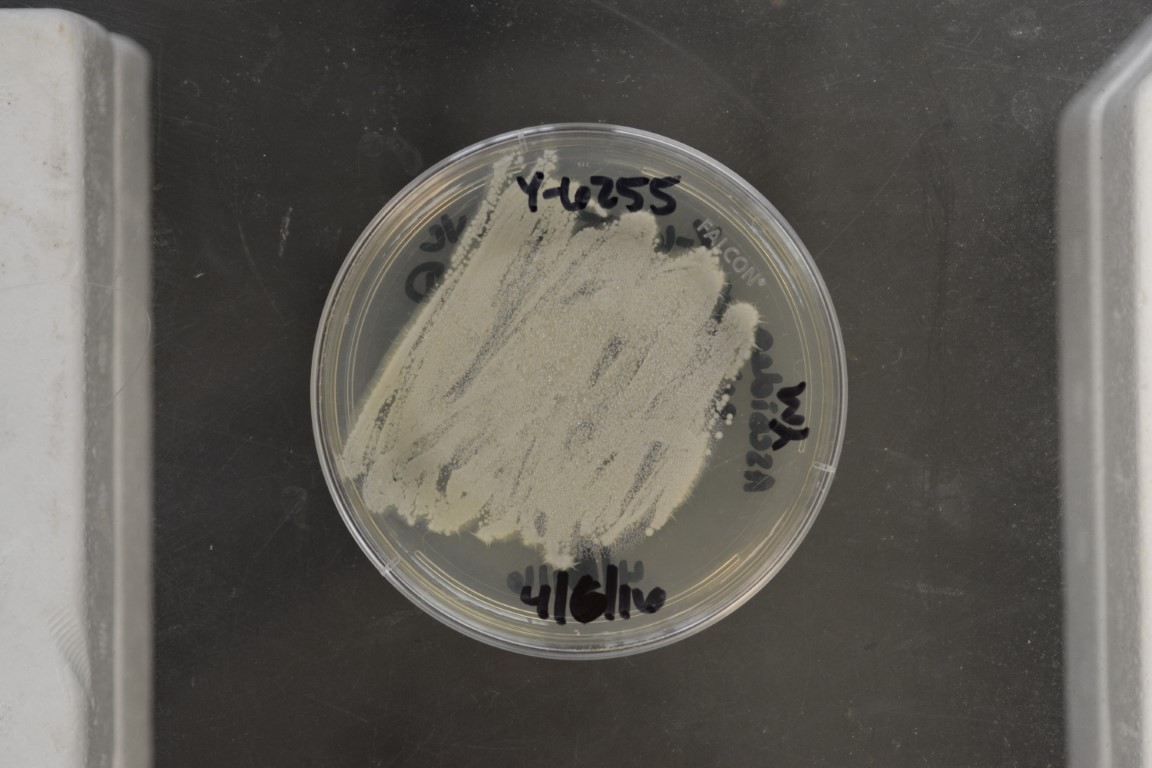

Ascoidea asiatica
NRRL Y-6255
Accession numbers in other collections:Grinbergs 948
Source:Grinbergs,Austral University of Chile,Valdivia,Chile
Isolated from(substrate):PTR,Araucaria pine
Substrate location:Andes Mountains,Chile
Genetic info:GenBank:LSU,SSU,EF-1 alpha,and RPB1(see Y-17632),RPB2(KC254877)
Growth media:Yeast Extract-Malt Extract-Peptone-Glucose(YM for yeasts)(number 6)
Optimum growth temperature:25C
Strain images:
NRRL_Y-6255_6.jpg